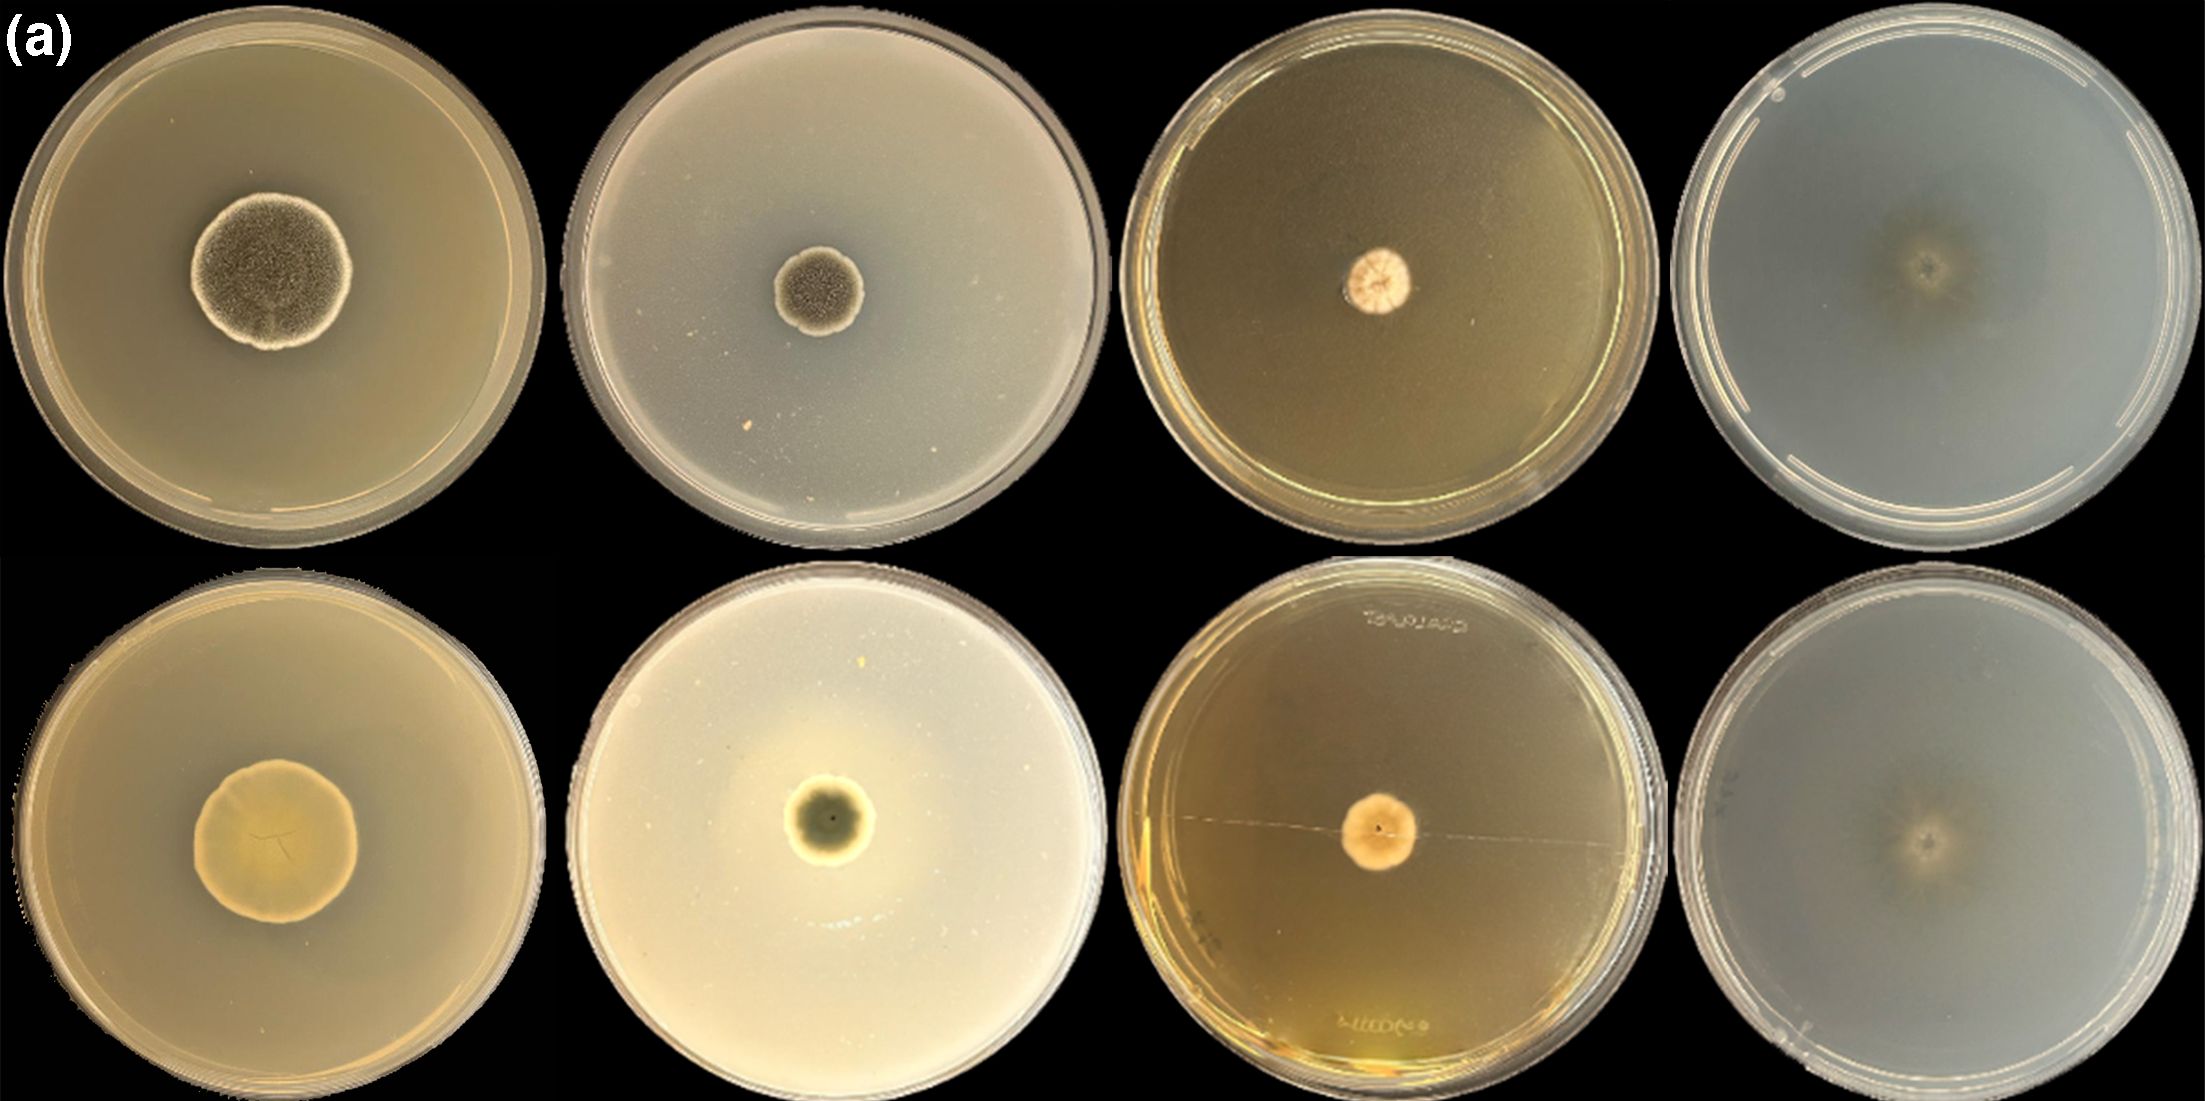
6283d0a8-d89c-4b00-a647-53f7ac283d58.jpg 1

New to Science: The latest discoveries from around the world
We may be approaching the end of the year, but there’s no slowing down for new discoveries coming in from across the world at the International Journal of Systematic and Evolutionary Microbiology. It’s a gift that keeps on giving!
First up, a novel fungus of the Microascaceae family was discovered from the body of a bat living in a cave in Brazil. If you're thinking that's a strange place to look for new fungi, bats are known as ideal carriers of fungi and other microorganisms due to their foraging behaviours and migration routes. Members of this family are known to colonise a variety of ecological niches but often become opportunistic pathogens in humans and animals. On the other hand, many species also produce bioactive metabolites such as anti-cancer and antimicrobial activities. Caves are natural hotspots for unique biodiversity - including for species of the genus Microascus. In this recent survey, caves of the Brazilian Caatinga region in the northeast of the country were surveyed as part of ongoing research into their ecosystems. Fungal strains were isolated from the trunk and back of healthy bats captured by hand nets. The hot dry region hosts plenty of unique species, including within its 3935 caves and cavities.

From a cave to the deep sea, a novel thermophilic bacterium with ferric iron reduction abilities was uncovered during a survey of the Indian Ocean Ridge, which lies in the ocean between Africa and Australia. Researchers from Xiamen, China, isolated Caloranaerobacter longqiensis from a hydrothermal sulphide sample collected in 2014 at between 2756 to 2395m depth. Members of the genus Caloranaerobacter have been reported from hydrothermal fields in deep sea, thermal springs in the Adean volcanic belt, and the Juan de Fuca Ridge. Fascinatingly, this suggests that members of this genus are highly related to tectonic activity and have the potential to be used as a biomarker of tectonic activity.
Next up, can you guess where a new bacterium called Puribacter membranae may have been found? If you’d guessed from a membrane bioreactor at a sewage treatment centre, you’d be completely right! A scientist at Nagaoka University of Technology in Japan identified the novel thermophilic bacterium from a biofilm on the membrane of the membrane bioreactor, which has become widely used in treatment plants. However, a significant operational challenge is membrane fouling mainly caused by the formation of microbial biofilms, which reduces treatment efficiency. Identifying the key bacterial components is crucial for understanding fouling mechanisms and developing effective control strategies.

Here’s a discovery in a case of mistaken identity. Nontuberculous mycobacteria are bacteria found in soil, dust, and water. But they can also cause infections in humans with symptoms including coughing, fever, and rashes. Mycobacterium gordonae complex is one of the most prevalent populations in aquatic habitats across multiple regions. However, pulmonary infections of M. gordonae have been reported numerous times. Several other species related to the M. gordonae complex have been introduced - these species have 99% sequence identity in their 16S rRNA, making them difficult to distinguish via conventional methods. When two recently isolated strains of what was thought to be M. gordonae were isolated from a human skin infection in Jiangsu, China, and analysed by whole genome sequencing, it was actually revealed to be a related novel species, proposed the name Mycobacterium camsae. The new member of the family exhibits orange, smooth and moist colonies and grows between 25-37°C.
Last but not least, a new discovery of a plant-dwelling bacteria, Caballeronia eucalypticola, in Qinzhou, China has been described this month. Can you guess from the name what plant it was found in? That's right, researchers isolated the novel bacterium from eucalyptus with bacterial wilt while surveying for the pathogen responsible. C. eucalpticola is Gram-negative, rod-shaped and non-spore-forming.

